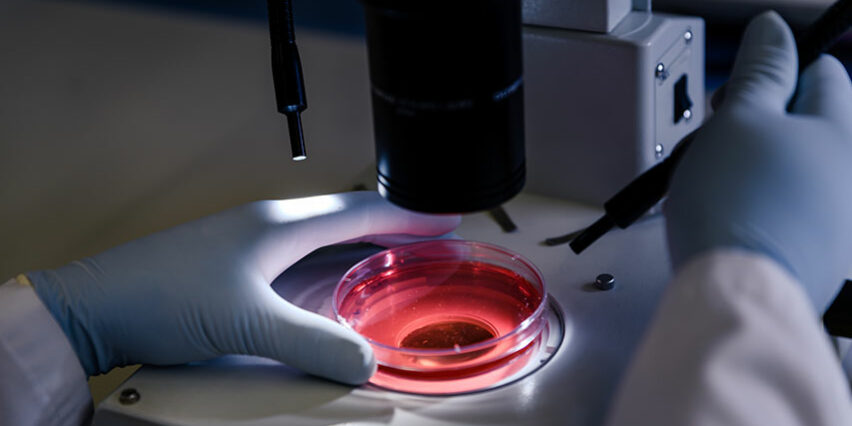
rischio biologico escherichia

Durata
1 ora
Periodicità
Variabile
Erogabilità
E-learning
Durata
1 ora
Periodicità
Variabile
Erogabilità
E-learning
Contenuti del corso
Corso di aggiornamento Il rischio biologico: escherichia coli, guano di volatili, legionella – Dirigente, Datore di lavoro
Agenti biologici
- I microrganismi
- Gli agenti biologici nel D. Lgs. n. 81/2008
Rischi biologici specifici: escherichia coli, guano di volatili, legionella
- Escherichia coli
- Guano di volatili
- Legionella
Obiettivi del corso
Il corso è finalizzato a fornire nozioni inerenti il tema degli agenti biologici al fine di ridurre i rischi di esposizione e adottare le idonee misure preventive e protettive.
Durata
Il corso ha una durata di un’ora.
Attestato di frequenza
Ogni partecipante, previo superamento di un test, riceverà un attestato di frequenza con credito formativo valido, ai sensi dell’Accordo Stato-Regioni 7 luglio 2016, su tutto il territorio nazionale.
Attestato di frequenza e Libretto Formativo del Cittadino potranno essere scaricati direttamente dalla piattaforma AIFOS.